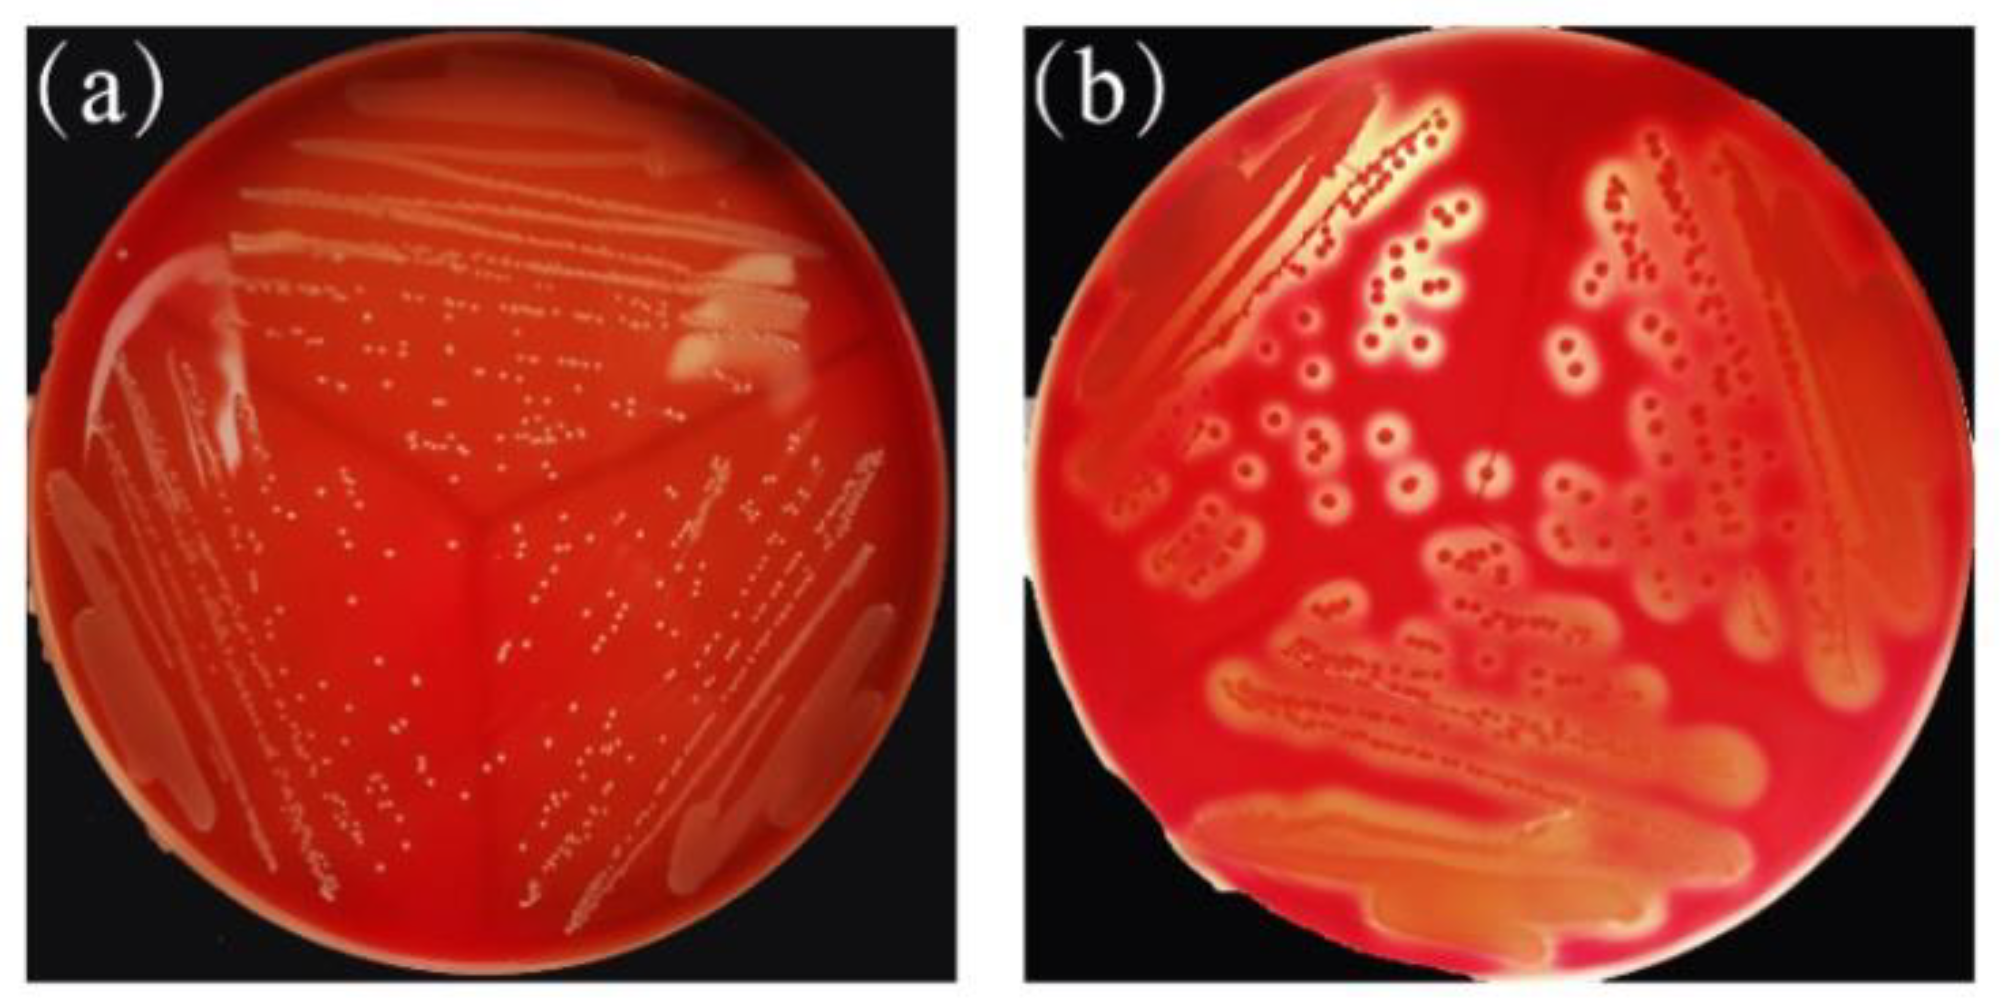
Molecules 25 04481 g008

1. Introduction
Enterotoxigenic Escherichia coli (ETEC) K88 is a pathogenic variant of
Escherichia coli that colonizes the surface of gastrointestinal cells when K88 infects the host and produces enterotoxins. This disrupts intestinal cellular electrolyte homeostasis, leading to fluid loss and, ultimately, to secretory diarrheal disease in newborns and piglets [
1,
2,
3]. Post-weaning diarrhea (PWD) caused by ETEC K88 has a high mortality rate. In China and the United States, the average annual mortality of PWD cases is as high as 15% and 15.5%, respectively, and the direct economic losses amount to more than US
$145 million [
4]. Antibiotics have been long used to reduce diarrhea and enhance growth performance in weaned piglets, while long-term use of antibiotics caused the emergence of resistant strains of animal and food-borne pathogens and further intestinal microbial imbalance, according to announcement No. 194 of the Ministry of Agriculture and Rural Affairs. China officially stopped the production, import, operation, and use of some pharmaceutical feed additives as of 1 July 2020. Mineral compounds, i.e., zinc oxide (ZnO), have traditionally been used to mitigate post-weaning ETEC-F4 diarrhea [
5,
6]. Some studies have shown that organic acids, functional feedstuffs (blood plasma), feed enzymes, prebiotic oligosaccharides, and clay minerals can potentially prevent PWD associated with ETEC [
7,
8]. Due to environmental concerns, there are risks associated with microbial resistance, as well as difficulty of material preparation; thus, it is necessary to find a new effective alternative to antibiotics for the treatment and prevention of bacterial infection diseases, including diarrhea caused by ETEC K88.
It has been confirmed that probiotics are microorganisms that can have beneficial effects on host health, mainly through the production of antibacterial substances, competition with pathogenic bacteria for nutrients and adhesion sites, and enhancing intestinal mucosal barrier integrity to play an immunomodulatory role against diarrhea in weaned piglets [
9]. Lactic acid bacteria (LAB) are the most frequently used probiotics, and several studies conducted on newly weaned piglets have noted that LAB can increase the abundance of lactobacilli and bifidobacteria, inhibit colonization of ETEC K88/F4, and improve production of short-chain fatty acid [
10]. Patil et al. [
11] found
Lactobacillus (L.) sobrius may be effective in the reduction of
E. coli F4 colonization, and may improve weight gain of infected piglets. Probiotic bacterium
L. rhamnosus was effective in ameliorating PWD induced by
E. coli K88, modulation of intestinal microflora, and enhancement of intestinal antibody defense [
12]. In conclusion, the above research indicate that LAB have a good inhibitory effect on pathogenic bacteria in piglets, especially on intestinal imbalance caused by ETEC K88.
Excellent LAB strains should have characteristics of fast propagation, easy cultivation, strains to maintain a certain activity during production and storage, and a certain tolerance to processing technology in application, and the excellent probiotic LAB still need to be discovered. This study evaluates the probiotic properties of the LAB strains isolated from different sources by determining their inhibitory activities to ETEC K88. After determining physiological and biochemical characteristics, cell surface properties and tolerance to simulated human gastrointestinal (GI) tract and bile test, strains that performed very well were selected identified by 16S rRNA gene sequencing and recA gene multiple detection. Strains that performed well in the probiotic test were then evaluated for safety, and the antimicrobial substances and organic acids produced by the fermentation of the strains were determined.
3. Discussion
In this study, to obtain functional probiotic bacteria that inhibit ETEC K88, more than 1100 LAB from different sources were tested and 40 isolates with an inhibition zone diameter of 18.00 cm or more were selected. ETEC is the main pathogenic bacterium that causes diarrhea in humans and young animals. As one of the indispensable floras with important physiological functions in human and animal bodies, LAB has the incomparable host bacteria advantages of other receptor strains. Sirichokchatchawan et al. [
13] reported the strain
L. plantarum showed antagonistic activity against
E. coli; a 6.0–9.00 mm inhibitor zone diameter was considered to be weak inhibition and marked as +. Moreover, 10.0–13.00 mm (intermediate inhibition) was marked as ++, 14.0–16.00 mm (strong inhibition) was marked as +++, and more than 17.00 mm (very strong) was marked as ++++ by the agar well diffusion method (including that of the hole puncher, 6.00 mm). While in this study, 13 isolates had more than 22.00 mm inhibition zones by using the same test method, the only difference being that the diameter of the hole puncher used was 10.00 mm.
One of the most important criteria for selecting LAB with probiotic properties is the ability to tolerate the environment of the gastrointestinal tract, with the pH of pig gastric juices being as low as 2.0, and bile with a pH of about 8.0. Dushku et al. [
14] isolated and identified 40 LAB strains from the gastrointestinal tract of local snails, which were artificially simulated to survive the gastrointestinal tract of only two strains. Rao et al. [
15] screened
L. plantarum AT4 for low pH and up to 0.5% bile salts. This study found 40 selected strains with excellent inhibition abilities; 13 homo-fermentative isolates could grow at 5 to 50 °C, and pH 3.0–10.0, and ferment glucose without producing gas. Considering that the temperature of weaned piglets is usually around 38.5 to 40 °C, the study examined acid production capacity, growth situation, low pH, and bile salt tolerance of selected LAB strains at 39 °C in addition to the optimal 30 °C conditions. As can be seen, all six selected strains showed stronger acid production ability under 39 °C, compared with 30 °C, and the growth of strains were not affected at 39 °C. Additionally, there was no significant difference between pH 2.5 and 0.5% bile salt resistance of the six selected LAB strains cultured at 30 and 39 °C. These results further suggest that the selected strains have potential for application as animal intestinal probiotics. Relative to heterofermentative LAB, producing a mix of lactic acid and acetic acid, homofermentative LAB promotes rapid fermentation, primarily producing lactic acid and rapidly reducing the pH, preventing the growth of other undesirable spoilage organisms, which indicated that these strains satisfied the demands for growth in relatively extreme environments. In a word, the excellent physiological and biochemical characteristics provide tremendous potential for selected strains in practical applications [
16].
Species identification is the basis for conducting scientific experiments, and the identification of the genus provides an indirect understanding of the bacteria’s habits, metabolism, and pathogenic patterns. In this study, phylogenetic trees were constructed based on the evolutionary distances of their 16S DNA sequences using the neighbor-joining method to identify selected LAB isolates at the species level. Selected strains were placed in clusters comprised of genera
Lactobacillus,
Weissella, and
Enterococcus, since strains ZA2, ZA3, ZA8, ZA10, and ZA28 were clearly assigned to the genus
Lactobacillus, and grouped in the
L. plantarum cluster on the phylogenetic tree with type strains
L. casei JCM 16167
T,
L. paraplantarum JCM 12533
T,
L. pentosus JCM 1558
T,
L. plantarum subsp.
plantarum JCM 1149
T, and
L. plantarum subsp.
argentoratensis JCM 16169
T, which could not be separated by 16S rDNA [
17]. By means of
recA gene, PCR amplification products, these five strains and
L. plantarum subsp.
plantarum JCM 1149
T had 318 bp products, while the negative control
L. casei and the other three type strains did not produce any amplicons; thus, ZA2, ZA3, ZA8, ZA10, and ZA28 strains could also be accurately identified as
L. plantarum subsp.
plantarum.
Adherence is a prerequisite for strains to colonize the gut and increase their viability. Only if the strain is able to adhere and colonize the intestinal tract can it promote immune regulation and stimulate the intestinal barrier and metabolism function [
18]. Adherence mainly includes cell surface hydrophobicity, self-aggregation, and co-aggregation to indicator bacteria, and its effect on intestinal cells. It has been shown that high hydrophobicity and auto-aggregation ability could promote the colonization of beneficial microorganisms in the gastrointestinal tracts of human hosts [
19]. In this study, ZA3 from weaned pig feces showed the highest hydrophobic activity (59.70%) and auto-aggregation ability (78.95%) in comparison to other LAB isolates tested, and the results are consistent with previous studies that the higher the surface hydrophobicity of these isolates, the stronger the self-aggregation ability [
20].
As a functional LAB, it should overcome several challenging environmental conditions, such as extremely high or low pH, salt, and bile, all are the most common factors [
21]. In the present study, it was found that ZA3 still had certain vigor after 4 h incubation in different acidic or bile salt environments, and exhibited 94.03% survival rate after 3 h in simulated gastric juice. The results obtained by Joghataei et al. [
22] displayed that
L. fermentum FH19 exhibited the highest survival rate (96%) after 3 h in SGF. Comparatively speaking, ZA3 had 98.88% survival ratio after the SIF phase in this study, indicating that it has a significant effect on SGF and SIF tolerance. Lee et al. [
23] reported
L. plantarum C182 possessed a significant level of resistance against 0.3% bile salts, while ZA 3 had vitality with OD value 1.115 after exposure to 0.5% bile salt for 6 h.
Safety is also one of the basic criteria for screening strains, LAB, especially
Lactobacillus, are usually considered safe. However, it has recently been discovered that
Lactobacillus and
Bifidobacterium are frequently isolated from diseased tissues, such as endocarditis and sepsis [
24,
25]. Therefore, it is necessary to re-evaluate their safety. In addition, the safety evaluation of probiotics has become more important with the isolation and application of new probiotics and the emergence of genetically modified probiotics. As isolated strains
Lactobacillus MMP4 wanted to be used in the dairy industry, Choudhary et al. [
26] used PCR to investigate whether strain MMP4 was an antibiotic resistant gene, and had safety parameters, such as gelatinase and hemolytic activity. In this study, all tested strains were PCR-negative for all the virulence factors, including virulence factor genes, biogenic amines genes, and antibiotic resistances genes, and antibiotic susceptibility and hemolytic activity, which are at risk for genetic transfer. The MIC of ZA3 to carbenicillin, cefamezin, ampicillin, clindamycin, erythromycin, and chloramphenicol were 0.5, 10, 1, 8, 1, and 8 µg/mL, which was consistent with the study by Nawaz et al. [
27], respectively. CCK-8 assay for the cytotoxicity of ZA3 on IPJC-2 cells showed that the strain was not cytotoxic. In addition, there was absence of hemolysis on blood agar, indicating that ZA3 could have potential as a safety probiotic candidate.
The ultimate goal of screening LAB is application, and the ability to utilize a wider variety of carbon sources, indicating that the strain ZA3 was easy to culture and has greater viability, which is of greater value in research and production.
There is a wide variety of antibiotics, and antibiotic inhibition spectrum varies by antibiotic type, when using probiotics instead of antibiotics, which probiotics should be used instead of antibiotics? Is it a complete replacement or a partial replacement? It is difficult for feed and breeding companies to make these decisions. Moreover, probiotics typically exhibit narrow killing spectrum, inhibiting only those bacteria that are closely related to them. Therefore, it is very important to screen strains with a wide antimicrobial spectrum and define the range of antimicrobial spectrum of the strains. In this study, results of screening for the potential antagonistic activity against important pathogens showed ZA3 exhibit broad-spectrum activity against a wide range of microorganisms, including gram-positive and gram-negative bacteria. Additionally, because the intestinal flora is a complex system and it is difficult to introduce new microorganisms into this competitive environment, it produces substances, such as bacteriocins, organic acids, short-chain fatty acids, and hydrogen peroxide that inhibit pathogens in the gut of growth, and reduce the occurrence of diarrhea [
28]. ZA3 had strong antimicrobial activity after excluding the effects of hydrogen peroxide by proteinase
K and eliminating hydrogen peroxide from the cell-free culture supernatants; however, all activities disappeared completely when the cell-free supernatant was treated with neutralizing pH, which indicated that the antimicrobial activity may be attributed to the production of organic acids. Similarly, as one of the antimicrobial compounds, Tirloni et al. [
29] and Bah et al. [
30] proposed organic acids can significantly inhibit the growth of pathogenic bacteria. Silva et al. [
31] reported
L. lactis subsp.
lactis presented antimicrobial activity against pathogens, which may be related to their lactic acid production, low pH values, and antimicrobial compounds. Furthermore, some research results showed that the main organic acids metabolites of LAB fermentation were pyruvate, lactic acid, acetic acid, citric acid, oxalic acid, and malic acid etc. [
29,
32,
33]. ZA3 mainly produced four kinds of organic acids: citric acid, succinic acid, lactic acid, and acetic acid, after 24 h fermentation, respectively. Lactic acid and acetic acid were significantly higher than other two acids. Such a conclusion is the same as that by Mun et al. [
34], who researched lactic acid and acetic acid in
L. plantarum fermentation broth as the main antibacterial active substances. In summary, it is worthwhile to investigate ZA3’s effect on diarrhea in animals induced by ETEC K88.
4. Materials and Methods
4.1. Screening of LAB Restrain ETEC K88 Activity
More than 1100 LAB strains isolated from weaned piglet feces, feed grass, Qula, rice silage, mixture silage, and corn silage were used in this study. All LAB isolates were incubated in de Man Rogosa Sharpe (MRS) broth at 30 °C.
Bacterial strains used in this article are shown in
Table 8. Among which, ETEC K88
Salmonella enterica ATCC 43971
T and
Enterococcus faecalis ATCC 29212
T were purchased from the China Veterinary Culture Collection Center (CVCC), China General Microbiological Culture Collection Center (CGMCC), and China Center of Industrial Culture Collection (CICC), respectively.
Staphylococcus aureus ATCC 6538
T,
Bacillus subtilis ATCC 19217
T,
Escherichia coli ATCC 11775
T,
Listeria monocytogenes ATCC 51719
T,
Pseudomonas aeruginosa ATCC 15692
T, and
Micrococcus luteus ATCC 4698
T were stored in the laboratory.
The antagonistic effect of LAB isolates against ETEC K88 were first determined by the agar well diffusion technique [
35]. The target bacteria ETEC K88 was grown in Luria–Bertani (LB) liquid culture medium and incubated at 37 °C with 180 rpm for 12 h. Subsequently, 100 uL of the overnight culture of K88 was added to LB agar medium, cooled to 50 °C, and shaken, mixing well before pouring onto the surface of the already coagulated LB agar plates. After solidification, 200 μL 16 h cultures of different strains were placed in the hole punched in the center of the plate by using a hole puncher (diameter 10.00 mm), with uninoculated MRS broth as negative, and penicillin (pc) as a positive control, respectively. Inhibition zone was measured after 2 h diffusion at 4 °C.
4.2. Molecular Identification of Representative Strains
4.2.1. 16S rRNA Analysis
The 16S rRNA gene of selected strains were amplified by PCR using the 27 F (5′-AGAGTTTGATCCTGGCTCAG-3′) and 1492 R (5′-GGTTACCTTGTTACGACTT-3′) universal primer sets. Amplifications by PCR were performed in a total volume of 50 μL DNA thermal cycler, which contained 25 μL 2 × Taq Plus Mastermix, 27 F and 1492 R primer 1 μL each, and finally add sterile distilled water and fix to 50 μL. Single colonies cultured for 24 h were added to each reaction system, separately, and the PCR condition was: initial activation at 94 °C for 5 min; 33 cycles at 94 °C for 50 s, 52 °C for 50 s and 72 °C for 50 s; and a final cycle at 72 °C for 17 min. The PCR products were placed in a 1% agarose gel and electrophoresed with Ethidium Bromide (EB) solution staining. The successful amplification was analyzed by sequencing service (MGI Tech Co., Ltd., Beijing, China), and resulting sequences were compared with sequences in the GenBank database using the BLAST program available on the National Center for Biotechnology Information website (
http://www.ncbi.nlm.nih.gov).
4.2.2. RecA Multiple Sequence
Means of partial amplification product comparison of the
recA gene was used to distinguish strains of
L. plantarum cluster, including
L. casei,
L. paraplantarum,
L. pentosus,
L. plantarum subsp.
plantarum, and
L. plantarum subsp.
argentoratensis [
17]. A multiplex PCR assay (20 μL) was performed with
recA gene-based primers para F (5′-GTCACAGGCATTACGAA AAC-3′), pent F (5′-CAGTGGCGCGGTTGATATC-3′), plan F (5′-CCGTTTATGCGGAACACC TA-3′), and pREV (5′-TCGGGATTACCAAACATCAC-3′). The PCR mixture was composed of primers para F, pent F, and pREV (0.25 μM each), 0.12 μM primer plan F, 25 μL 2 × Taq Plus Mastermix, add sterile distilled water to 40 μL. Single colonies including type strains
L. casei JCM 16167
T (negative control),
L. paraplantarum JCM 12533
T,
L. pentosus JCM 1558
T,
L. plantarum subsp.
plantarum JCM 1149
T, and
L. plantarum subsp.
argentoratensis JCM 16169
T, and strains of this cluster, indistinguishable after 16S rRNA analysis, were added to each reaction system, separately. The PCR condition was initial denaturation at 94 °C for 5 min, 33 cycles of denaturation at 94 °C (30 s), annealing at 56 °C (10 s), elongation at 72 °C (30 s), and final extension at 72 °C for 5 min. The PCR products were visualized in a 2% agarose gel in 0.5 × TAE (20 mM Tris-acetate, 0.5 mM EDTA, pH 8.0) buffer.
4.3. Cell Surface Hydrophobicity and Auto-aggregation of Representative Strains
The cell surface hydrophobicity and auto-aggregation assay were performed according to Somashekaraiah et al. [
20] and Wang et al. [
36], respectively, and both with some modifications. LAB strains cultivated in MRS broth at 30 °C for 16 h were washed twice with phosphate-buffered saline (PBS) (8000×
g, 4 °C, 10 min) and resuspended in PBS buffer followed by absorbance measurement at 600 nm (OD 600, marked as A0).
For cell surface hydrophobicity analysis, 3 mL cell suspension was blended with 1 mL xylene; the two-phase system was mixed by vortexing for 2 min, and incubated at 37 °C without shaking for 30 min (for separation of the aqueous and organic phases). The water phase was carefully removed and its absorbance at 600 nm was measured (OD 600, marked as A1). The percentage of cell surface hydrophobicity (H%) was calculated using the following formula:
As for auto-aggregation, bacterial cell suspensions were mixed by vortexing for 10 s and incubated at room temperature for 8 h, the upper suspension was checked for absorbance at 600 nm at time intervals of 0, 2, and 8 h (OD 600, the absorbance at each particular time marked as different Atime). The auto-aggregation was measured (in percentage) using the following formula:
4.4. Determination of Growth Curve and Acid Production Capacity of Representative Strains
Each single LAB colony was picked and added into 20 mL sterile MRS, and the optical density at 600 nm (OD 600) and colony forming units (CFU) /mL were determined immediately at 2, 4, 6, 8, 10, 12, 14, 16, 18, 20, 22, and 24 h after inoculation at 30 and 39 °C, respectively. The pH of each fermentation solution was determined at 0, 6, 12, 18, 24, 30, 36, 42, and 48 h after inoculation at 30 °C and 39 °C, respectively.
4.5. Low pH and Bile Salt Tolerance of Representative Strains
MRS broth at pH 2.5 and MRS solution containing 0.5% (wt/vol) bile salt were used to assess low pH and bile salt tolerance, and pH 6.8 and no bile salt MRS broth were set as control, respectively. Each LAB isolate was incubated at 30 °C and 39 °C in different acidic and bile salt environments for 0, 2, 4, and 6 h, respectively, and then incubated at 30 °C for 20 h, measuring the biomass by optical density at 600 nm.
4.6. Survival of Representative Strains in GI Fluids
The simulated gastric fluid (SGF) and simulated intestinal fluid (SIF) were performed as described by Massounga et al. [
37] with modifications. Briefly, for SGF, 3.5 g/L pepsin was suspended in 0.2% w/v sterile NaCl solution and adjusted pH to 2.0, made the total volume of the solution up to 100 mL, and filtered through a 0.22 μm filter membrane. For SIF, 1 g/L trypsin, 18 g/L bile salt from ox and 11 g/L NaHCO
3 were suspended in 0.2% w/v sterile NaCl solution, adjusted the pH of the solution 6.8, and, again, brought the total solution volume to 100 mL with 0.22 μm membrane filtration. Moreover, 2% 10
8 CFU/mL LAB solution was added to 20 mL SGF and incubated for 3 h (SIF was 4 h). Viable colonies were determined with plate counts on MRS agar after 0, 3, and 7 h incubation.
4.7. Pathogenicity Evaluation of Strain ZA3
4.7.1. Safety Evaluation
The strain ZA3 was screened for the presence of genetic traits related to virulence factors, biogenic amines, and antibiotic resistance using the PCR protocols [
38], and referring to the approach of Shankar et al. [
39].
Enterococcus faecalis ATCC 29212
T that harbor the target virulence genes (ace, cylA, and gelE) was used as positive control, and Milli-Q water as positive control, respectively. The target genes include gelE (gelatinase) (F: 5′-TATGACAATGCTTTTTGGGAT-3′, R: 5′-AGATGCACCCG AAATAATATA-3′), cylA (cytolysin) (F: 5′-GAATTGAGCAAAAGTTCAATCG-3′, R: 5′-GTCTGTCTT TTCACTTGTTTC-3′), ace (adhesion of collagen) (F: 5′-ACTCGGGGATTGATAGGC-3′, R: 5′-GCTGC TAAAGCTGCGCTT-3′), vanA (vancomycin resistance) (F: 5′-TCTGCAATA GAGATAGCCGC-3′, R: 5′-GGAGTAGCTATCCCAGCATT-3′), tetM (tetracycline resistance) (F: 5′-ATTACACTTCCGATTT CGG-3′, R: 5′-GTTAAATAGTGTTCTTGGAG-3′), hdc (histidine decarboxylase) (F: 5′-AGATGGTAT TGTTTCTTATG-3′, R: 5′-AGACCATACACCATAACCTT-3′), tdc (tyrosine decarboxylase) (F: 5′-GA YATNATNGGNATNGGNYTNGAYCARG-3′, R: 5′-CCRTARTCNGGNATAGCRAARTCNGTRTG-3′), and odc (ornithine decarboxylase) (F: 5′-GTNTTYAAYG CNGAYAARCANTAYTTYGT-3′, R: 5′-ATNGARTTNAGTTCRCAYTTYTCNG GG-3′).
4.7.2. Antibiotic Susceptibility
The minimum inhibitory concentration (MIC, µg/mL) of 10 antibiotics was determined by agar dilution method according to the Clinical and Laboratory Standards Institute (CLSI) standards. Each experiment was performed on MRS agar plates containing different antibiotics, including carbenicillin, cefamezin, ampicillin, gentamicin, norfloxacin, clindamycin, penicillin, erythromycin, chloramphenicol, and amikacin. Antibiotics were prepared at a range of concentrations from 0.125 to 512 µg/mL by twofold dilution, and each concentration was tested in triplicate. All isolates were inoculated on MRS agar containing antibiotics at 37 °C for 24 h, and strains cultivated on MRS agar plates without antibiotics were used as controls.
4.7.3. Hemolytic Activity
Hemolytic activity was analyzed on blood agar as the manufacturer’s instructions. Fresh bacterial ZA3 was streaked on Columbia blood agar plates, and Staphylococcus aureus ATCC6538T was used as positive control.
4.7.4. Toxicity Test of the ZA3 Strain against Eukaryotic Cells
Cell viability was determined by the Cell Counting Kit-8 (CCK-8) assay (Nanjing Jiancheng Institute of Bioengineering, Nanjing, China). The experiment was divided into normal cell and LAB treatment groups, and the multiplicity of infection (MOI) was set to three gradients, 1, 2, and 3, with each well performed in sextuplicate. IPEC-J2 cells (1 × 10
5 cells/well) were seeded into 96-well tissue culture plates with 100 μL per well. After cells grown in a humidified chamber at 37 °C under 5% CO
2, collected that it reached 80% confluence, CCK-8 was used to stain the cells for about 2, 4, 12, and 24 h after being treated by ZA3, respectively. The optical density was measured at 450 nm using a microplate spectrophotometer.
As: experimental well (including cell-containing medium, CCK-8 and ZA3);
Ac: control well (including cell-containing medium and CCK-8);
Ab: blank well (cell culture medium without cells, CCK-8).
4.8. Antimicrobial Activity
The antimicrobial activity of ZA3 against pathogenic bacteria was assessed by the method of agar well diffusion, E. coli ATCC 11775T, Pseudomonas aeruginosa ATCC 15692T, Staphylococcus aureus ATCC6538T, Bacillus subtilis ATCC 19217T, Listeria monocytogenes ATCC 51719T, Micrococcus luteus ATCC 4698T, and Salmonella enterica ATCC 43971T were used as indicator bacterium.
4.9. Carbohydrate Utilization Patterns of ZA3
Thirty common carbon sources, including glycerol, D-arabinose, L-arabinose, ribose, D-xylose, galactose, D-glucose, D-fructose, mannose, L-sorbose, rhamnose, dulcitol, inositol, mannitol, sorbitol, salicin, cellobiose, maltose, lactose, melibiose, saccharose, trehalose, melezitose, D-raffinose, starch, xylitol, L-arabitol, gluconate, N-acetyl glucosamine, and amygdalin were used to detect carbohydrate utilization patterns of ZA3 by replacing the carbon source, each in turn, in the MRS medium.
4.10. Identification of the Antimicrobial Substance of ZA3
The antimicrobial substance of ZA3 was assessed according to Ni et al. [
40] and exclusion experiments for acid and catalase inhibition, and protease (proteinase K, trypsin, and pepsin) degradation were performed, respectively. For the pH stability assay, the ZA3 bacteria suspension was adjusted to pH values ranging from 3.0 to 10.0 by 0.2 M HCl or 0.2 M NaOH. For the hydrogen peroxide, the ZA3 bacteria suspension was treated with 0.5 mg/ mL catalase to confirm if it had catalase inhibition. The effects of protease on antimicrobial activity were determined by incubating the ZA3 suspension, separately, with 1 mg/mL proteinase K, trypsin, and pepsin at 37 °C for 2 h, and collecting the supernatant of overnight LAB cultures in MRS broth by centrifugation at 8000×
g for 10 min to assay.
4.11. Determination of Organic Acids Produced by ZA3
The organic acid produced by ZA3 was determined with high performance liquid chromatography (HPLC) (column: Carbomix H-NP10: 8%, 7.8 × 300 mm, Sepax Technologies, Inc., Newark, DE, USA; detector: DAD, 214 nm, Agilent 1200 Series, Agilent Technologies Co., MNC, Santa Clara, CA, USA; eluent: 2.5 mmol/L H2SO4, 0.6 mL/min; temperature: 55 °C). Overnight ZA3 bacteria cultures of LAB grown in MRS broth were centrifuged at 8000 × g for 10 min and filtered through a 0.22 μm filter membrane. The organic acids, lactic acid, acetic acid, propionic acid, butyric acid, succinic acid, citric acid, and malic acid were detected.
4.12. Statistical Analyses
Each test was performed in triplicate. Data were analyzed by one-way analysis of variance (ANOVA) or paired t-test (SPSS 22.0). All data were shown as mean ± standard error of mean (SEM), and p < 0.05 indicated significant difference in statistics.